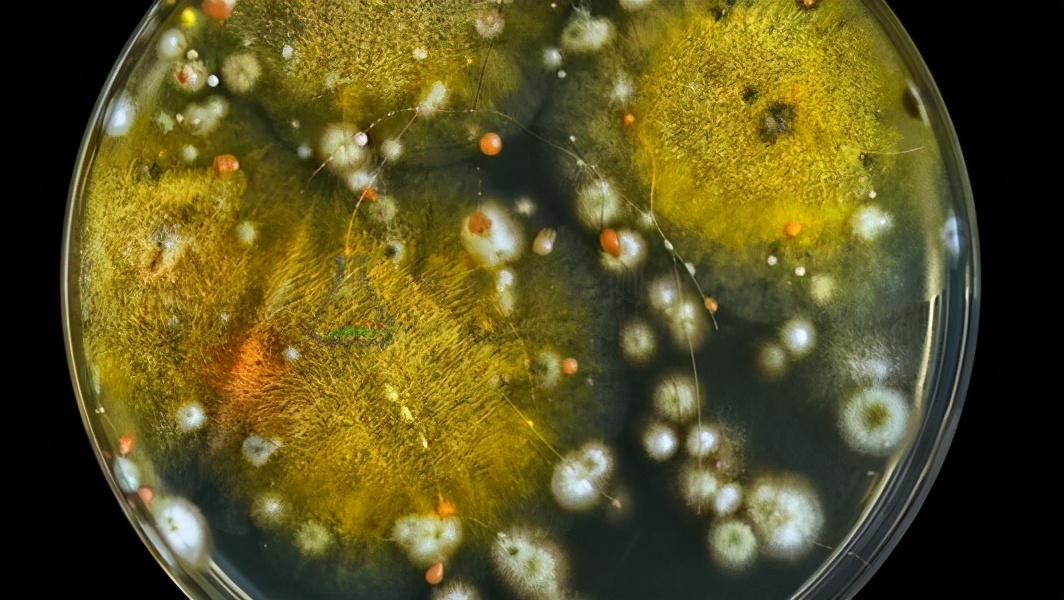
海带是属于植物还是美食,海带可食用的部分是它的叶片吗

海带很常见,从小吃到大,我也挺喜欢吃,凉拌爽口、煲汤亦佳,实乃美味食材。
不过,要突然告诉您,从小吃到大的海带它并不是一直认为的植物,或许许多人一时会接受不了。
海带它看起来是植物、摸起来是植物、吃起来也是植物,它咋就不是植物了?
古语告诉我们,勿以貌取人,小改一个字,勿以貌取带,同样适用。

通常来说,我们习惯把海带称为藻类,不过这种说法过时已久,如今只是个习惯性称呼。藻类是个五花八门的泛指,海带所在的褐藻早已被植物界开除了。
按照生物分类学的最新分类,海带被分在了真核域,真核域里共有8个界:动物界、古菌界、细菌界、假菌界、菌物界、植物界、原生动物界、病毒界。
海带,就在里面的假菌界(Chromista)里,又翻译为“藻界”或“藻物界”,属于真核生物域的一个分支。
假菌界是新增加的分类,可以理解为相对真菌界而言。科学家原来认为这些假菌和真菌很相似,但在一些方面还有差异,归入真菌界说不过去,所以设立了假菌这一个界。
哪知,随着对这些假菌的研究越来越深入,大家发现假菌与真菌的差异点越来越多。比如它们的水生种类在无性繁殖时产生有2条鞭毛的游动孢子,陆生种类则产孢子囊和孢囊孢子,真菌则没有,这是非常明显的差异,如此来看,这个假菌界还真是有先见之明了。
假菌界与动物界、植物界平行,显然海带不能算植物、也不能算动物了。
那么,海带怎么看怎么像植物,为啥它会被分入假菌界呢?
海带确实有根,但它的根其实不是根。
虽然有点绕,但不难理解。植物从根部吸取水和养分,海带的根完全不是这么回事,它的根其实是它用来固定自己的固着器,海带用根来附着在海底的岩石上,以免自己被风浪卷跑。
举个栗子更容易理解。
由于海带的根就相当于它的手,养殖海带时并不需要让它在海底生长,那样不利于采集,只要让它的手能抓住东西固定就行。

于是渔民们就会用粗尼龙绳给海带搭好架子,让它的根缠绕在绳子上,海带就能茁壮成长了。
与一般认知中植物向上生长不同,倒吊在架子上的海带其实是向下生长的。人工种植的海带一般能长到2-3米,5-6米的也不少见,如果让它继续疯长还能更长。
这里另外再多说一句,海带头上脚下生长并非来自古代智慧,根据记录是在1953年才在山东水产养殖场培育成功,从此海带由野生变为近海养殖,这是我国科研人员的创举。

海带的根是假根,那它如何吸收水和养分?答案是它全身都有叶绿体能进行光合作用制造有机物,也就是全身都能从环境中吸收水分和无机盐。
有点乱,海带有叶绿体,能进行光合作用又是个什么鬼,这不该是植物特有的技能吗?
很长一段时间,科学家也是这么认为的,直到他们发现海带的线粒体和叶绿体并不是它自身的固有结构。
海带体内有线粒体和叶绿体,不过它们的关系比较特别,属于一种共生关系的产物。
怎么产生共生的,原因比较复杂,根据现在的基因和DNA分析,科学家目前的结论是所有真核生物的线粒体都来自同一次“内共生”,叶绿体就复杂得多,它至少经过5次才和海带演化成如今的关系。

简单来理解,就相当于海带的祖先囫囵吞下了这些细菌,但顽强的细菌并没被消化掉,反而入驻了真核细胞内部,把自己变成了细胞的一部分细胞器。
如此一来竟然形成了双赢,真核细胞给这些细菌保护和营养,让它们过上了衣食无忧的好日子。一些能有氧呼吸的细菌成为线粒体,给细胞提供了源源不断的能量;另一些能光合作用的细菌成为叶绿体,为细胞制造了充足的氧气和糖分。
海带的假菌界特征分类也正是来自它们的叶绿体,这些内共生的藻细胞拥有4层细胞膜,从里到外依次是,细菌的细胞膜,植物细胞内部的膜,植物的细胞膜,海带细胞内部的膜。
植物的细胞核已退化消失,可以看做是一个退化的植物,植物细胞内含有大量褐藻素,所以我们看到的海带会呈现黄褐色。
不得不感叹,生命真是太奇妙了。

也可以理解为,海带相当于一个近似透明的生物,它偶然吃下一颗青菜,结果发现青菜在肚子里还能光合作用,源源不断提供能量。
这下好了,捕食的麻烦也省去了,海带就此无欲无求在家宅起来,演化成了今天的模样。那我们总不能因为它吃了口青菜就把它当成植物,所以就有了海带的分类。
怎么准确地描述海带,可以说它是保留了光合作用的茸鞭生物,与草履虫的关系远近于和植物的关系,所以之前它被分到“囊泡虫界”,随着分类的调整,现在被划入假菌界。
在最新发布的中国国家地理杂志里,同样是把海带称为茸鞭类,也就是不等鞭毛类的。

事实上,生物学也是个与时俱进的学科,随着人类对生物认知的越来越深入,分类也需要不断调整。
在早期,局限于科技水平,1886年海克尔的三界学说只有植物界、动物界、原生生物界。当时原生生物界就是个框,感觉模糊难以分类的就往里装。
1969年,魏特克提出五界分类系统,提出了原核生物、原生生物、真菌、动物、植物五界。
到了现代,卡瓦尼·史密斯的八界分类系统被大家公认:真细菌界、古细菌界、原始动物界、原生动物界、植物界、动物界、真菌界、假菌界。
分得越来越细没什么不好,这代表目前人们的认知水平,是人类分子系统学进步和超微结构深入研究的结果。
分类学的发展也就是个以貌取人到以内在取人的发展过程。或许若干年后,海带又被划入到其他界里,大家也不要奇怪。

说了这么多,或许有人认为在分类上搞这么多名堂意义不大,海带只需要是食物就够了,至于它是植物还是动物没那么重要。
但科学从不考虑人的口味。
生物分类学是试图揭露生物之间最本质联系的一门理论。
它的意义在于研究生物类群间的异同以及异同程度,对于人类阐明生物间的亲缘关系、进化过程和发展规律意义极大。如果不对物种进行鉴定,不把它们放到系统里合适的位置上加以分类,这棵进化树上庞大的生物数量捋都捋不清。
而随着我们对物种基因和微观结构的认识,我们会越来越接近真相。
海带不是植物,那也就带来更有意思的话题,它与线粒体、叶绿体的共生具体是如何形成的,这对生物科技将来的发展有现实意义。
海带如此独特,所以一拳超人里面有海带怪,国产科幻片《海带》里海带还成了外星海带人。艺术虽然夸张,总还是来源于生活。

如果这么说,那素食主义者又要犯愁了,海带该算是素菜还是荤菜呢?
这点其实倒无须担心,通常在我们的认知里,不属于动物界的生物做成的食物就是素菜。
比如蘑菇,蘑菇不是植物而是真菌,它也是素菜。至少现在,海带还不算是动物,那么海带自然也算是素菜。

当然,您要喜欢说它是海鲜,那也不能说错。